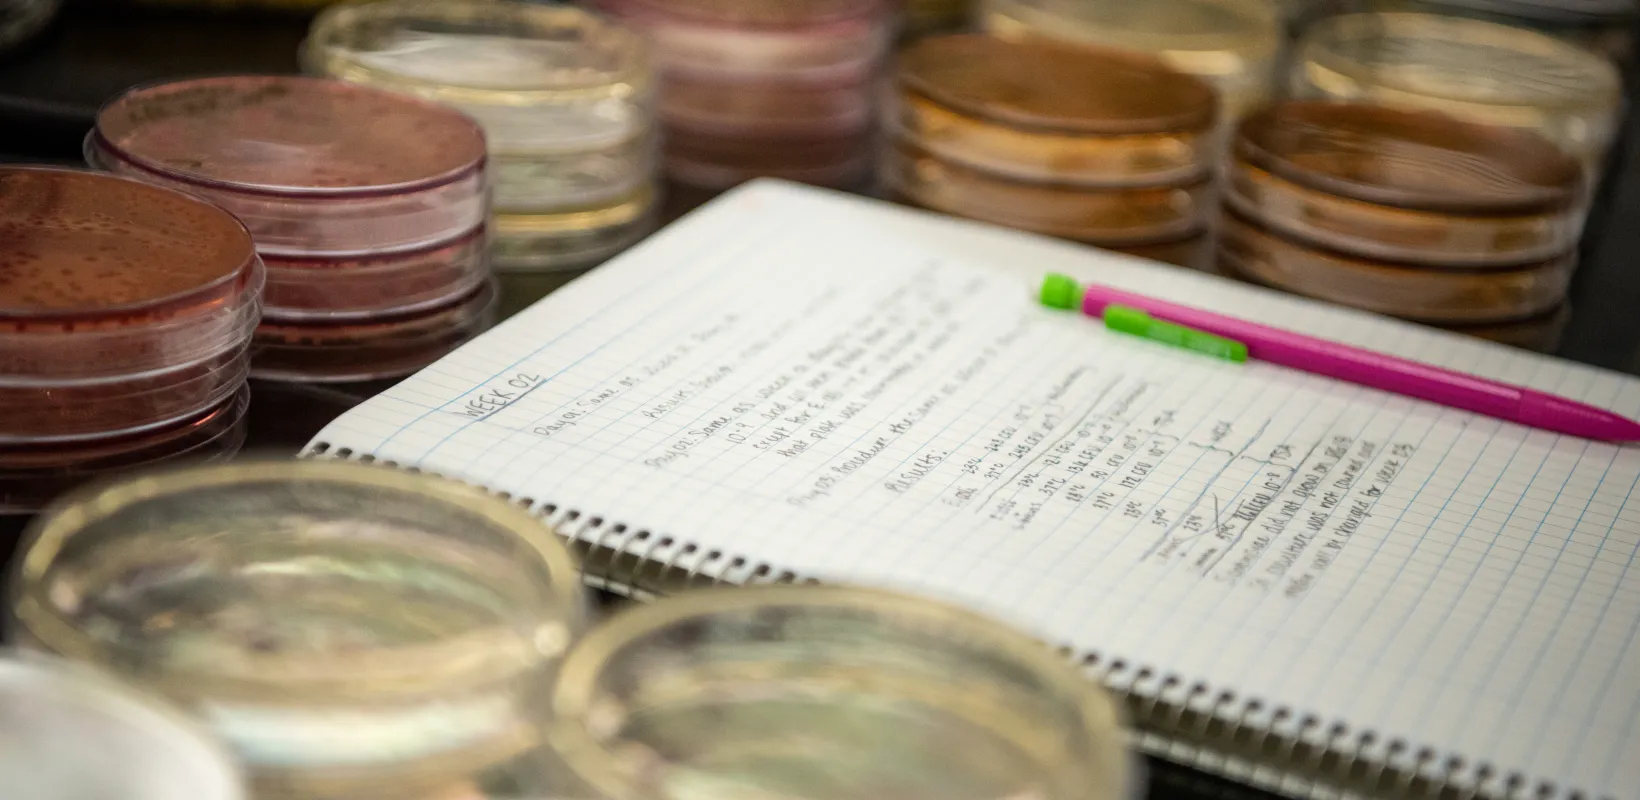

What is Pre- Mortuary Science?
Pre-Mortuary Science is not a major and does not lead to a degree from NDSU. Students planning to finish a 4-year Mortuary Science bachelor's degree at the University of Minnesota may do their first two years of pre-professional coursework at NDSU.
What is Mortuary Science?
Mortuary Science Practitioners, also known in the industry as funeral directors and morticians, are members of a human services profession, members of the community in which they serve, and those engaged in the funeral service profession.
What type of education is required?
To become a funeral director in most states, one must complete a 2- year (Associate degree) or 4-year (bachelor’s) degree program in mortuary science. While requirements for licensure vary state-by-state, four states (Michigan, Minnesota, Ohio and Oklahoma) in the United States - require a 4-year bachelor’s degree to practice as a funeral director.
All students must take the National Board Exam before receiving their degree as required by The American Board of Funeral Service Education (ABFSE).
What should I major in at NDSU, if I want to go to mortuary science school?
Please be aware that pre-mortuary science is not a major. Students typically complete the prerequisites (with a grade of C or higher) and transfer to a mortuary science program at a school of their interest.
Coursework required for most mortuary science schools*
- Financial Accounting (3 credit minimum) - ACCT 200
- General Biology w/ a Lab (4 credit minimum) - BIOL 111/100L
- General Chemistry w/ a Lab (4 credit minimum) - CHEM 117/117L or CHEM 121/121L
- Freshman Composition (3 credit minimum) - ENGL 110 or ENGL 111
- Statistics (3 credit minimum) - STATS 330
- General Psychology (3 credit minimum) - PSYC 111
- Public Speaking (3 credit minimum) - COMM 110
Recommended courses
- Human Anatomy (3 credit minimum) - BIOL 220 & BIOL 221
- Computer Science (3 credit minimum) - CSCI 114
- Advanced English writing course - ENG 324
- Introduction to Sociology (3 credit minimum) - SOC 110
- Introduction to Philosophy - PHIL 111
- Elements of Economics - ECON 105
- Introduction to Religion - RELS 100
- **Personal & Community Health - HNES 217
- **Medical Terminology- CHP 125/VETS 115
* Prerequisite courses vary by program
**These courses are not prerequisite requirements, but they are Program of Mortuary Science degree requirements at the University of Minnesota. It is recommended that students complete these courses before starting the Program.
Experiences
Observation in a funeral home is advised though not required. Since requirements vary by program and state, students need to stay informed of the course requirements for admission into the mortuary science program and the licensure requirements.
Pre- mortuary science students are encouraged to participate in student organizations at NDSU such as the Pre-Med Club and American Medical Student Association and Allied Health (AMSA). These organizations are run by students with similar career goals and provide an opportunity for others to discuss career plans and gather details about the professions they are interested in.
Application/Admission Information
Students who wish to make application to a mortuary science program should do so through the website of the respective program. Most of our students transfer to the University of Minnesota to earn the Bachelor of Science (B.S.) degree program with a major in mortuary science, upon completion of 60 semester credits with grades of C or higher. Applicants must have a minimum cumulative GPA of 2.5 to be considered for admission.
Resources
For additional information about a career in funeral service, the following resources are available: